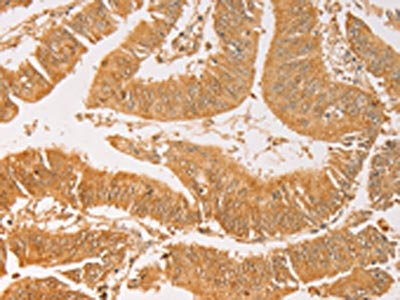

AK2 Antibody
-
中文名稱:AK2兔多克隆抗體
-
貨號:CSB-PA443063
-
規格:¥1100
-
圖片:
-
The image on the left is immunohistochemistry of paraffin-embedded Human cervical cancer tissue using CSB-PA443063(AK2 Antibody) at dilution 1/40, on the right is treated with fusion protein. (Original magnification: ×200)
-
The image on the left is immunohistochemistry of paraffin-embedded Human colon cancer tissue using CSB-PA443063(AK2 Antibody) at dilution 1/40, on the right is treated with fusion protein. (Original magnification: ×200)
-
Gel: 10%SDS-PAGE, Lysate: 40 μg, Lane 1-7: Human placenta tissue, A549 cells, mouse brain tissue, hepG2 cells, Raji cells, human fetal liver tissue, hela cells, Primary antibody: CSB-PA443063(AK2 Antibody) at dilution 1/300, Secondary antibody: Goat anti rabbit IgG at 1/8000 dilution, Exposure time: 20 seconds
-
-
其他:
產品詳情
-
Uniprot No.:
-
基因名:AK2
-
別名:Adenylate kinase 2 antibody; adenylate kinase 2, mitochondrial antibody; Adenylate kinase isoenzyme 2 antibody; ADK2 antibody; AK 2 antibody; ak2 antibody; ATP AMP transphosphorylase antibody; ATP-AMP transphosphorylase 2 antibody; EC 2.7.4.3 antibody; KAD2_HUMAN antibody; mitochondrial antibody
-
宿主:Rabbit
-
反應種屬:Human,Mouse,Rat
-
免疫原:Fusion protein of Human AK2
-
免疫原種屬:Homo sapiens (Human)
-
標記方式:Non-conjugated
-
抗體亞型:IgG
-
純化方式:Antigen affinity purification
-
濃度:It differs from different batches. Please contact us to confirm it.
-
保存緩沖液:-20°C, pH7.4 PBS, 0.05% NaN3, 40% Glycerol
-
產品提供形式:Liquid
-
應用范圍:ELISA,WB,IHC
-
推薦稀釋比:
Application Recommended Dilution ELISA 1:2000-1:5000 WB 1:500-1:2000 IHC 1:50-1:200 -
Protocols:
-
儲存條件:Upon receipt, store at -20°C or -80°C. Avoid repeated freeze.
-
貨期:Basically, we can dispatch the products out in 1-3 working days after receiving your orders. Delivery time maybe differs from different purchasing way or location, please kindly consult your local distributors for specific delivery time.
-
用途:For Research Use Only. Not for use in diagnostic or therapeutic procedures.
相關產品
靶點詳情
-
功能:Catalyzes the reversible transfer of the terminal phosphate group between ATP and AMP. Plays an important role in cellular energy homeostasis and in adenine nucleotide metabolism. Adenylate kinase activity is critical for regulation of the phosphate utilization and the AMP de novo biosynthesis pathways. Plays a key role in hematopoiesis.
-
基因功能參考文獻:
- Genetic variants of AK2 activates tenofovir for HIV therapy. PMID: 29641561
- Reticular dysgenesis -patient derived induced pluripotent stem cells can recapitulate disease phenotype which can be rescued by AK2 overexpression. PMID: 29462620
- In conclusion, our data suggest that SIRPalpha signaling through SHP-2-PI3K-Akt2 strongly influences osteoblast differentiation from bone marrow stromal cells. PMID: 27422603
- AK2 deficiency compromises the mitochondrial energy metabolism required for differentiation of human neutrophil and lymphoid lineages. PMID: 26270350
- results suggest that AK2 is an associated activator of DUSP26 and suppresses cell proliferation by FADD dephosphorylation, postulating AK2 as a negative regulator of tumour growth. PMID: 24548998
- AK2 is indispensable for neutrophil differentiation, indicating a possible causative link between AK2 deficiency and neutropenia in reticular dysgenesis. PMID: 24587121
- These results suggest that, acting in concert with FADD and caspase-10, AK2 mediates a novel intrinsic apoptotic pathway that may be involved in tumorigenesis. PMID: 17952061
- The alpha-borano or alpha-H on PMEA and PMPA were detrimental to the activity of recombinant human AMP kinases 2 PMID: 18404568
- Biallelic mutations in AK2 (adenylate kinase 2) in seven individuals affected with reticular dysgenesis and sensorineural deafness, were identified. PMID: 19043416
- The gene encoding the mitochondrial energy metabolism enzyme adenylate kinase 2 (AK2) is mutated in individuals with reticular dysgenesis. PMID: 19043417
顯示更多
收起更多
-
相關疾病:Reticular dysgenesis (RDYS)
-
亞細胞定位:Mitochondrion intermembrane space.
-
蛋白家族:Adenylate kinase family, AK2 subfamily
-
組織特異性:Present in most tissues. Present at high level in heart, liver and kidney, and at low level in brain, skeletal muscle and skin. Present in thrombocytes but not in erythrocytes, which lack mitochondria. Present in all nucleated cell populations from blood,
-
數據庫鏈接:
Most popular with customers
-
-
YWHAB Recombinant Monoclonal Antibody
Applications: ELISA, WB, IHC, IF, FC
Species Reactivity: Human, Mouse, Rat
-
Phospho-YAP1 (S127) Recombinant Monoclonal Antibody
Applications: ELISA, WB, IHC
Species Reactivity: Human
-
-
-
-
-